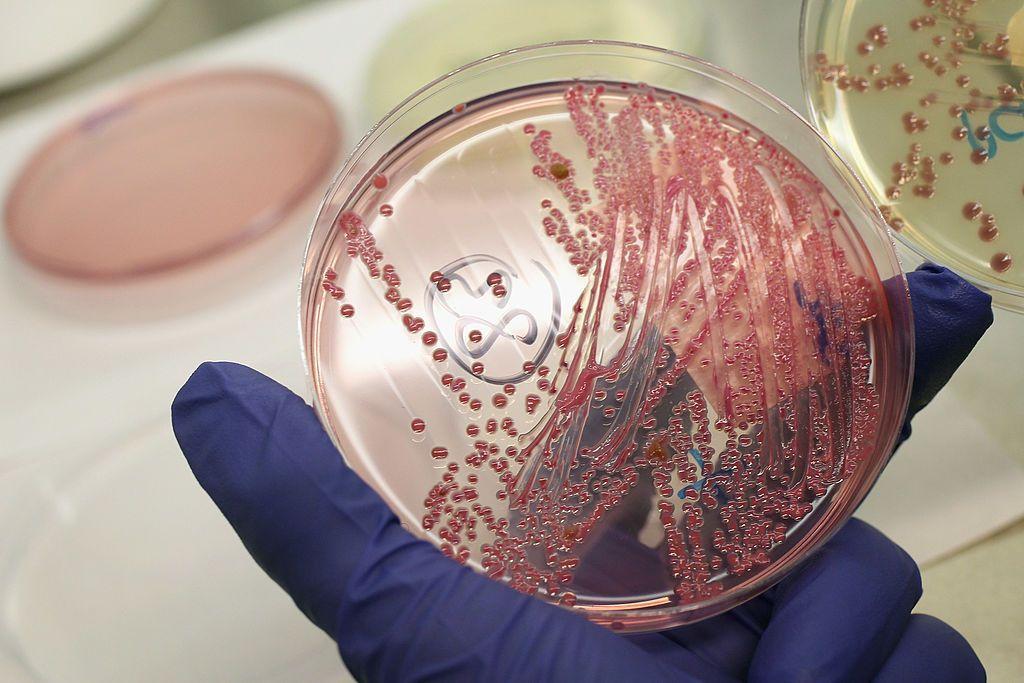
Ešerihija koli: Kako izbeći opasno trovanje hranom 1 Ešerihija koli

Dve velike epidemije bolesti koje se prenose hranom nedavno su bile glavna vest, a uzrok obe bila je ista bakterija – Ešerihija koli.
Jedna osoba je umrla, a najmanje 39 je obolelo od Ešerihije koli povezane sa upakovanom organskom šargarepom koja se prodaje u raznim radnjama prehrambenih proizvoda širom Sjedinjenih Država (SAD), navodi Centar za kontrolu i sprečavanje bolesti (CDC).
Tokom prethodne epidemije Ešerihije koli, takođe u SAD-u, koju je uzrokovao seckani luk u nekim hamburgerima MekDonaldsa, preminuo je čovek u oktobru, a 34 ljudi je lečeno u bolnici.
Šta znamo o uzrocima ovih zaraza i kako možemo da se zaštitimo?
- Bakterije otporne na antibiotike ubijaju milione ljudi, pokazala studija
- Kako da zaustavimo otpornost bakterija na antibiotike
- Šta možete da jedete, a šta ne ako imate dijareju
Šta je Ešerihija koli
„Ešerihija koli je bakterija koju svi imamo u crevima”, kaže za BBC profesor Hju Penington, mikrobiolog i vodeći stručnjak za Ešerihiju koli u Ujedinjenom Kraljevstvu (UK).
„Velika većina od stotina različitih varijanti Ešerihije koli je prilično bezopasna, osim ako ne stignu na pogrešno mesto”.
Ali postoje sojevi koji proizvode otrov, među kojima je Ešerihija koli O157, koji stvara Shiga toksin i ponekad se naziva STEC (Shiga toxin-producing Escherichia coli).

Nalazi se u crevima i izmetu mnogih životinja, posebno goveda, ali kada se prenese na ljude, ovaj i drugi sojevi mogu da izazovu ozbiljne zdravstvene komplikacije.
Infekcije Ešerihijom koli su relativno česte.
U pregledu Američke nacionalne medicinske biblioteke iz 2023. godine, procenjuje se da je svake godine u svetu bilo 2,8 miliona slučajeva zaraze Ešerihijom koli.
Da li je Ešerihija koli smrtonosna
Ešerihija koli može da bude smrtonosna, iako retko u poređenju sa brojem ljudi koji se godišnje zaraze ovom bakterijom.
Studija CDC-a o slučajevima zaraze u SAD-u između 1982. i 2002. godine pokazala je da je od više od 8.000 prijavljenih slučajeva umrlo 40 ljudi, što je oko jedan smrtni slučaj na 200 zaraženih.
Posebno osetljivi na komplikacije povezane sa teškom infekcijom su veoma mladi i veoma stari ljudi.

Kako se prenosi Ešerihija koli
Bakterija Ešerihije koli živi u crevima goveda, ovaca, koza, i jelena.
Ljudi se razboljevaju kada „jedu stajsko đubrivo od krava koje imaju ovu bakteriju”, kaže profesor Penington.
To se dešava zato što sitni tragovi Ešerihije koli mogu lako da dospeju na hranu i površine i veoma su zarazni.
Soj O157 je nekada u SAD-u bio poznat kao „bakterija hamburgera” jer je bio povezan sa hamburgerima koji su bili nedopečeni (krvavi).
Međutim, Penington kaže da rizik predstavlja svaka namirnica na koju je moglo da dospe stajsko đubrivo.
„Povrće je bilo izvor zaraze jer se na njivi možda koristilo stajsko đubrivo.
„Na primer, u Americi izbijaju velike epidemije izazvane sokom od jabuke jer jabuke padnu na zemlju u voćnjaku u kom su se šetale životinje”.
Veći rizik predstavljaju i nepasterizovano mleko, puter i sirevi, jer kao mlečni proizvodi mogu da budu izloženi kontaminaciji izmetom.
Bakterije mogu da se prenose i vodom, a Ešerihija koli takođe može da se prenese dodirom sa životinjama ili zaraženim ljudima.
- Rak creva: Kako proveriti stolicu
- Da li se antibioticima uništavaju i neophodne bakterije u ljudskim crevima
Kako može da se izbegne zaraza Ešerihijom koli
Temeljno pranje ruku, bezbedno rukovanje hranom, kao i izbegavanje određenih namirnica mogu mnogo da pomognu smanjenju rizika od zaražavanja Ešerihijom koli.
Bil Marler je advokat za bezbednost hrane koji poslednjih 30 godina zastupa ljude obolele od Ešerihije koli, salmonele, listerioze (bakterijske crevne infekcije), i drugih bolesti koje se prenose hranom.
On se pojavljuje u Netfliksovom dokumentarcu Otrovani: Prljava istina o vašoj hrani, koji je počeo na osnovu knjige o njegovom prvom velikom slučaju.
On je za BBC govorio o hrani koju ne treba jesti ako želite da izbegnete da se razbolite.
Sirove klice

Marler kaže da ne jede sirove klice kao što su lucerka, mungo pasulj, detelina, i jestive izdanke mahunarki.
Oni su povezane sa nekim od najvećih zaraza koje se prenose hranom u svetu.
U 2011. godini, epidemija povezana sa semenima piskavice, uglavnom u Nemačkoj, uzrokovala je bubrežnu insuficijenciju kod do 900 ljudi, i više od 50 smrtnih slučajeva u 16 zemalja.
„Seme se kontaminira tokom uzgaja na otvorenom.
„Kada ih unesete unutra i stavite ih vodu da proklija, to je savršen medij za razmnožavanje bakterija”, kaže Marler.
„Ne znam nikoga u industriji bezbednosti hrane ko jede sirove klice”.
Meso koje nije dobro pečeno
Kod mlevenog mesa, svaka bakterija koja se nalazi na površini mesa se umeša, i zbog toga je važno da se hamburgeri dobro ispeku.
A nije potrebno mnogo bakterija da se čovek ozbiljno razboli.
„Oko 50 bakterija Ešerihije koli dovoljno je da vas ubije, a 100.000 može da stane na vrh igle.
„To nije nešto što možete da vidite, okusite ili omirišete.
„Jedini siguran način da se to izbegne je da se hamburger dobro ispeče”, kaže Marler.
On preporučuje da insistirate da se vaš hamburger sprema na temperaturi od 69 stepeni Celzijusa da bi se uništili svi patogeni.
A što se tiče odrezaka, opasnost je obično manja, jer se tokom spremanja bakterije spolja ubijaju.
Pranje i kuvanje voća i povrća
Velika epidemija Ešerihije koli uzrokovana spanaćem izbila je 2006. godine, kada je obolelo više od 200 ljudi, a do pet je umrlo u SAD-u.
Marler je zastupao većinu ljudi pogođenih ovom zarazom.
Na kraju je utvrđeno da je bakterija potekla sa farme spanaća u Kaliforniji na koju su zalazile životinja, a njihov izmet je kontaminirao spanać Ešerihijom koli.
Kada je ubran i odnese u objekat gde je opran tri puta, bakterija se prenela na druge namirnice preko kojih se proširila svuda po zemlje i uzrrokovala bolest mnogih ljudi.
„Da li je ugodnost toga da dobijete opranu zelenu salatu vredna rizika da više ljudi dolazi u dodir sa njom?
„Ako više ljudi dolazi u dodir sa njom a ona se kontaminira, onda se to širi prilično brzo”, kaže Marler.
- „Ne gutajte antibiotike na svoju ruku, neke infekcije su sve žilavije i otpornije na njih“
- Šta se desi kad antibiotici prestanu da deluju
- Kako bakterije utiču na raspoloženje
Pratite nas na Fejsbuku, Tviteru, Instagramu, Jutjubu i Vajberu. Ako imate predlog teme za nas, javite se na [email protected]
Pratite nas na našoj Facebook i Instagram stranici, ali i na X nalogu. Pretplatite se na PDF izdanje lista Danas.




